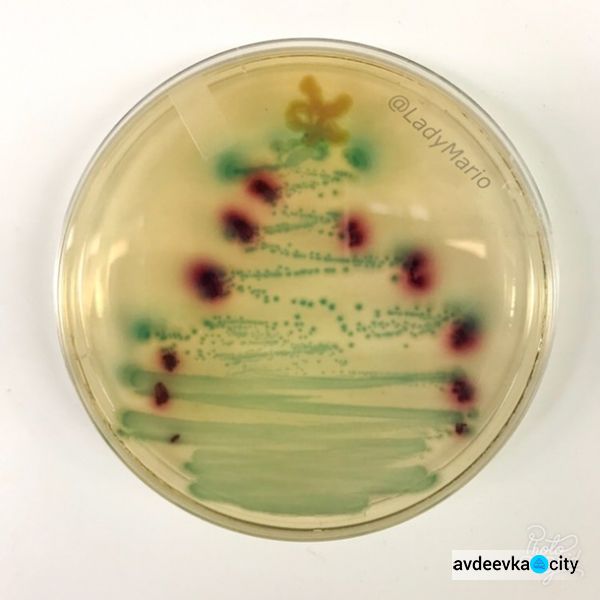

Пользователи Сети публикуют снимки со своими новогодними елками, и некоторые отличаются незаурядной креативностью и фантазией.
Странным "деревьям" определенно далеко до традиционных и вероятно, у их создателей очень хорошее чувство юмора.
Снимками необычных елок пользователи активно делятся на своих страницах в социальных сетях.




